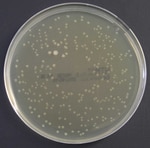
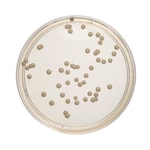

Search
- Home
- Shop All Products
- General Prepared Media Plates
Haemophilus Test Medium (HTM)
Perform effortless susceptibility testing of Haemophilus influenza with ready-to-use Thermo Scientific™ Oxoid™ Haemophilus Test Medium (HTM). The medium forms part of the recommended methods of the Clinical and Laboratory Standards Institute (CLSI)1.

XLD Agar
Isolate and identify Salmonella and Shigella spp. with Thermo Scientific™ XLD Agar, a selective medium that relies on xylose fermentation, lysine decarboxylation and production of hydrogen sulphide for the primary differentiation of shigellae and salmonellae from non-pathogenic bacteria.

R2 A Agar
Enumerate heterotrophic bacteria from drinking water samples with ready-to-use Thermo Scientific™ Oxoid™ R2A Agar. This nutritionally reduced medium was specially designed to enhance the recovery of stressed and chlorine damaged bacteria from treated water samples.

JEMBEC System with Thayer Martin Agar Improved (M-L) w/anisomycin, colistin, vancomycin, trimethoprim
Selectively isolate Neisseria gonorrhoeae and Neisseria meningitidis with Thermo Scientific™ Remel JEMBEC System with Thayer Martin Agar Improved (M-L) w/anisomycin, colistin, vancomycin and trimethoprim. Johnston introduced a medium to grow N.

Mueller-Hinton Agar with 5% Sheep Blood
Perform effortless Antimicrobial Susceptibility Tests (AST) for fastidious organisms using Thermo Scientific™ Mueller-Hinton Agar with 5% Sheep Blood prepared media plates. A precise clear zone will help to determine if the bacteria is resistant or sensitive to the antibiotics used.

TCBS Cholera Medium
Selectively isolate pathogenic Vibrio species with Thermo Scientific™ Oxoid™ TCBS (Thiosulfate Citrate Bile Salts Sucrose) Cholera Medium. The medium has shown to be the most satisfactory and reproducible formula regardless of the complex composition1.
Sabouraud Dextrose Agar with Chloramphenicol
Isolate, cultivate and differentiate dermatophytes, fungi and yeasts, such as Candida albicans, using acidic pH Thermo Scientific™ Sabouraud Dextrose Agar with Chloramphenicol.

CCDA Selective Medium
Isolate Campylobacter spp. using blood-free Thermo Scientific™ CCDA Selective Medium, which conforms to ISO 10272-1 and 10272-2.

JEMBEC System w/Thayer Martin Agar Modified (w/nystatin, colistin, vancomycin, trimethoprim)
Isolate Neisseria gonorrhoeae and Neisseria meningitidis with Thermo Scientific™ Remel JEMBEC System w/Thayer Martin Agar Modified (w/nystatin, colistin, vancomycin, trimethoprim). Johnston introduced a medium to grow N. gonorrhoeae in 24 hours1 and this was the advent of GC Agar Base.

无菌沉降板 R2A
使用 Thermo Scientific™ Remel™ 无菌 R2A 沉降板,对饮用水中的异养细菌进行计数和培养。使用营养较低的培养基、较低的孵育温度和更长的孵育时间,刺激从处理过的水中回收的应激和耐氯细菌的生长。美国公共卫生协会 (APHA) 在水和废水检验的标准方法中推荐使用 R2A 琼脂1。关于水质(如异养细菌平板计数)的信息可用于评估处理工艺的效率。
